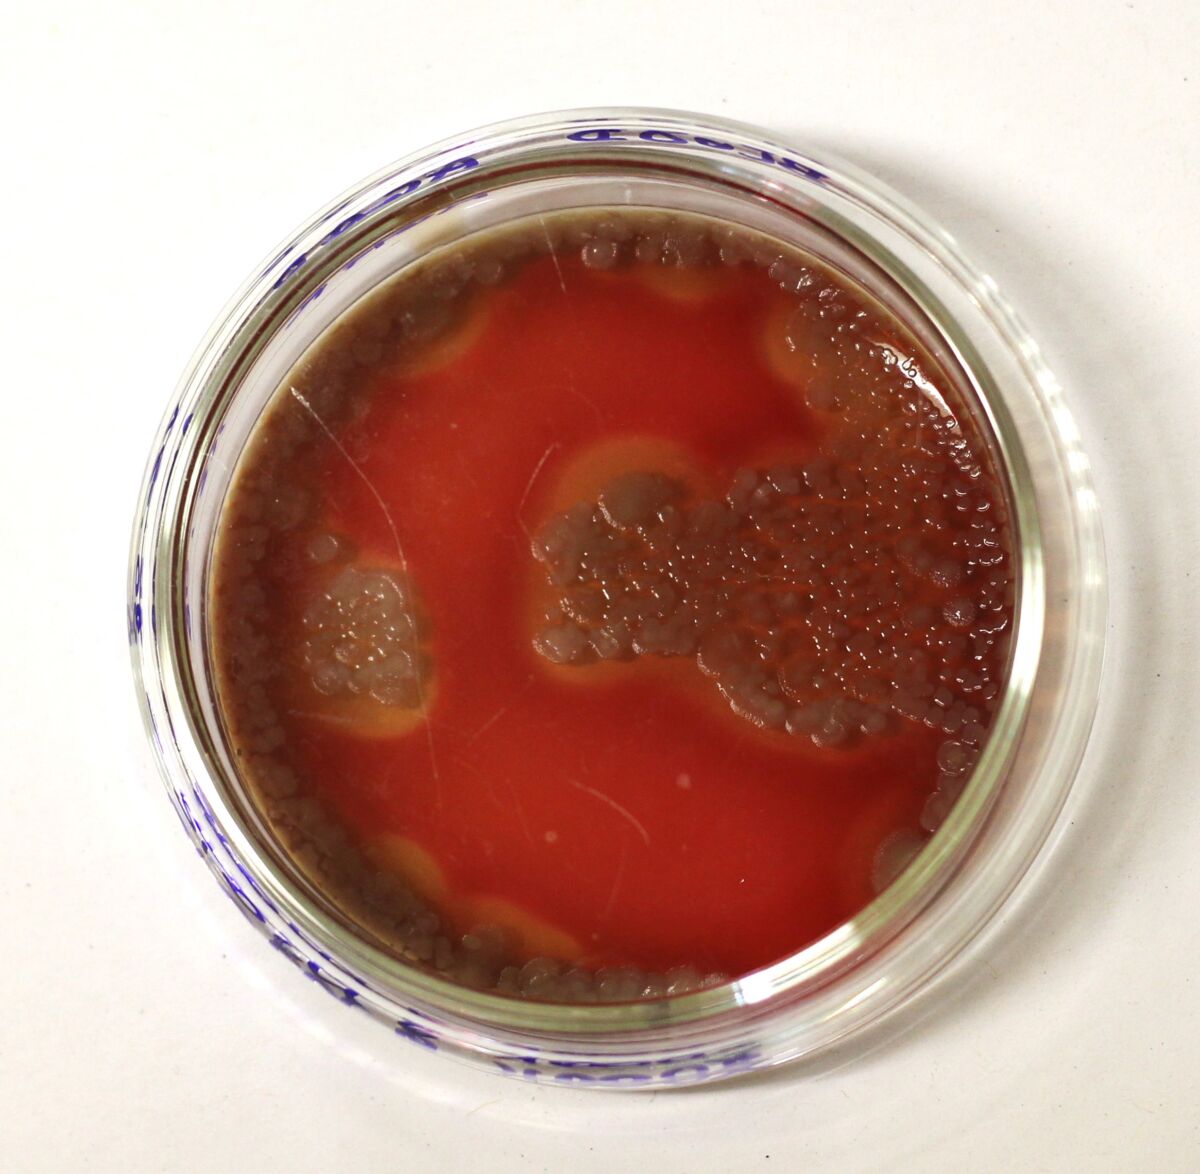

Intervju Otvorenjem izložbe Znakovi vremena poljsko-njemačke umjetnice Karoline Żyniewicz u utorak, 17. rujna u 19 sati počinje nova programska sezona u KONTEJNER-u. Umjetnica, istraživačica i predavačica Karolina Żyniewicz provodi kolovoz i rujan u Zagrebu, na rezidenciji European Media Art Platform (EMAP) u okviru koje istražuje sjećanja i priče vezane uz pandemiju Covid-19 s fokusom na medicinske maske kao simbole tog izazovnog razdoblja. Na projektu je surađivala s Mihaelom Gibom (kompjuterski razvoj) i Gjinom Šutićem (laboratorijski savjetnik).
Żyniewiczin rad integrira antropologiju, umjetnost i biologiju, koristeći transdisciplinarni pristup za ispitivanje materijalnih tragova pandemije. Umjetnica upotrebljava prikupljene medicinske maske i radi ntervjue koji bilježe osobna iskustva pandemije te analizira maske prema standardnim laboratorijskim protokolima. Te nalaze pretvara u umjetničke izraze, uključujući pisane tekstove, videozapise, fotografije i biološke uzorke, a cijeli rad će kulminirati na performativnoj izložbi.
U suvremenim bio-filozofskim teorijama, pojam života više se ne artikulira na tradicionalan način, s centralnim mjestom rezerviranim za pojedinačne jedinke, već se promatra kroz prizmu suživota. Živa su bića međusobno simbiotički povezana, a granice među njima nejasne. Koronavirus SARS-CoV-2 koji uzrokuje COVID-19 jedna je u nizu potvrda tih teorija koje razotkrivaju zablude o čvrstoj granici između pojedinaca. Glavna metoda zaštite od virusa pokazala se maska koja je postala simbol biopolitičke prilagodbe novim okolnostima.
Karolina Żyniewicz u svom se radu usredotočila upravo na taj element redizajna ljudske prisutnosti, prikupljajući korištene i odbačene maske, arhivirajući biološke otiske nepoznatih ljudi. Arhivu maski nadopunila je sustavno bilježeći iskustva pandemijskog života svojih poznanika. U ovom kompleksnom radu, Żyniewicz propituje koncepte kontaminacije i čistoće, ali i socijalne i biološke granice koje su postale nejasne u kontekstu globalne pandemije. Maske postaju nositeljice sjećanja i bioloških podataka, otvarajući pitanje biološkog nasljeđa koje ostavljamo za sobom. Projekt Znakovi vremena ne samo da služi kao podsjetnik na ranjivost ljudskog života, već i kao sredstvo otpora zaboravu i otuđenju.
Više o radu umjetnice publika će moći doznati u četvrtak 26. rujna u 19 sati, kada će se u KONTEJNER-u održati razgovor s umjetnicom.
Karolina Żyniewicz (PL/DE) je umjetnica, istraživačica i predavačica koja živi i radi u Berlinu, liminalno biće koje djeluje i postoji između različitih konteksta i disciplina. Diplomirala je na Fakultetu vizualnih umjetnosti na Akademiji likovnih umjetnosti Strzemiński u Łódźu, a doktorirala je kulturne znanosti na Sveučilištu u Varšavi. Rad u laboratoriju smješta njene radove u područje bio-umjetnosti, iako izbjegava koristiti taj termin, a glavni joj je fokus „život“ u širem smislu, njegovo biološko i kulturno značenje.
Više detalja možete pronaći ovdje.